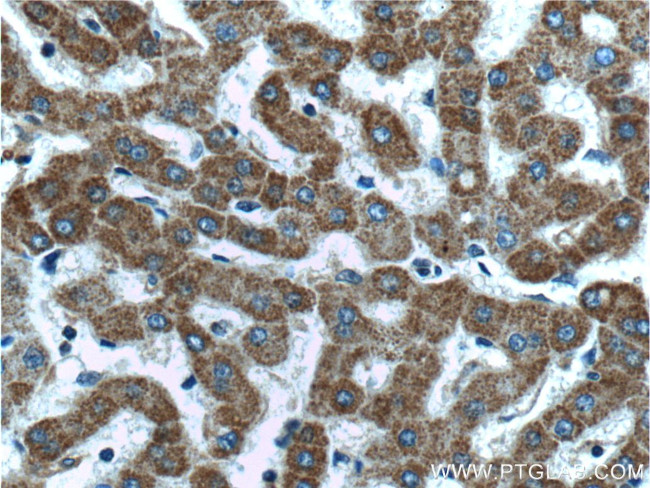
MTF1 Antibody in Immunohistochemistry (Paraffin) (IHC (P))

Search
Proteintech
MTF1 Polyclonal Antibody
{{$productOrderCtrl.translations['antibody.pdp.commerceCard.promotion.promotions']}}
{{$productOrderCtrl.translations['antibody.pdp.commerceCard.promotion.viewpromo']}}
{{$productOrderCtrl.translations['antibody.pdp.commerceCard.promotion.promocode']}}: {{promo.promoCode}} {{promo.promoTitle}} {{promo.promoDescription}}. {{$productOrderCtrl.translations['antibody.pdp.commerceCard.promotion.learnmore']}}
产品信息
25383-1-AP
种属反应
已发表种属
宿主/亚型
分类
类型
抗原
偶联物
形式
浓度
规格
纯化类型
保存液
内含物
保存条件
运输条件
产品详细信息
Immunogen sequence: VSDVPPSTG NSASLSLPLV LQPGLSEPPQ PLLPASAPSA PPPAPSLGPG SQQAAFGNPP ALLQPPEVPV PHSTQFAANH QEFLPHPQAP QPIVPGLSVV AGASASAAAV ASAVAAPAPP QSTTEPLPAM VQTLPLGANS VLTNNPTITI TPTPNTAILQ SSLVMGEQNL QWILNGATSS PQNQEQIQQA SKVEKVFFTT AVPVASSPGS SVQQIGLSVP VIIIKQEEAC QCQCACRDSA KERASSRRKG CSSPPPPEPS PQAPDGPSLQ LPAQTFSSAP VPGSSSSTLP SSCEQSRQAE TPSDPQTETL SAMDVSEFLS LQSLDTPSNL IPIEALLQGE EEMGLTSSFS K (404-753 aa encoded by BC014454)
靶标信息
This gene encodes a transcription factor that induces expression of metallothioneins and other genes involved in metal homeostasis in response to heavy metals such as cadmium, zinc, copper, and silver. The protein is a nucleocytoplasmic shuttling protein that accumulates in the nucleus upon heavy metal exposure and binds to promoters containing a metal-responsive element (MRE).
仅用于科研。不用于诊断过程。未经明确授权不得转售。
生物信息学
蛋白别名: Metal regulatory transcription factor 1; metal-responsive transcription factor 1; metalloregulatory transcription factor; MRE-binding transcription factor; MRE-binding transcription factor-1; Transcription factor MTF-1; unnamed protein product; zinc regulatory factor
基因别名: MTF-1; MTF1; Thyls; ZRF
UniProt ID: (Human) Q14872, (Mouse) Q07243
Entrez Gene ID: (Human) 4520, (Mouse) 17764